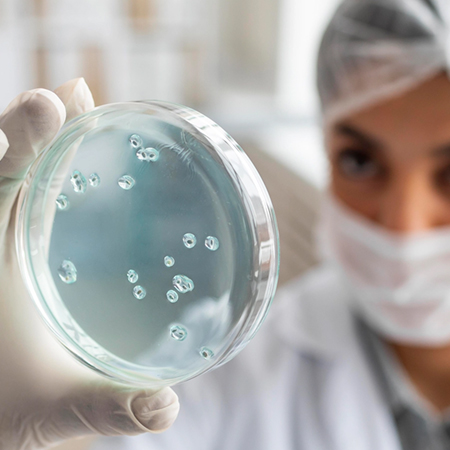

Patient Evaluation & Cell Harvesting
Comprehensive health screening and imaging studies. Minimally invasive bone marrow aspiration from iliac crest. Alternative sources: Adipose tissue extraction or umbilical cord blood (allogeneic). Cell count analysis and viability testing.